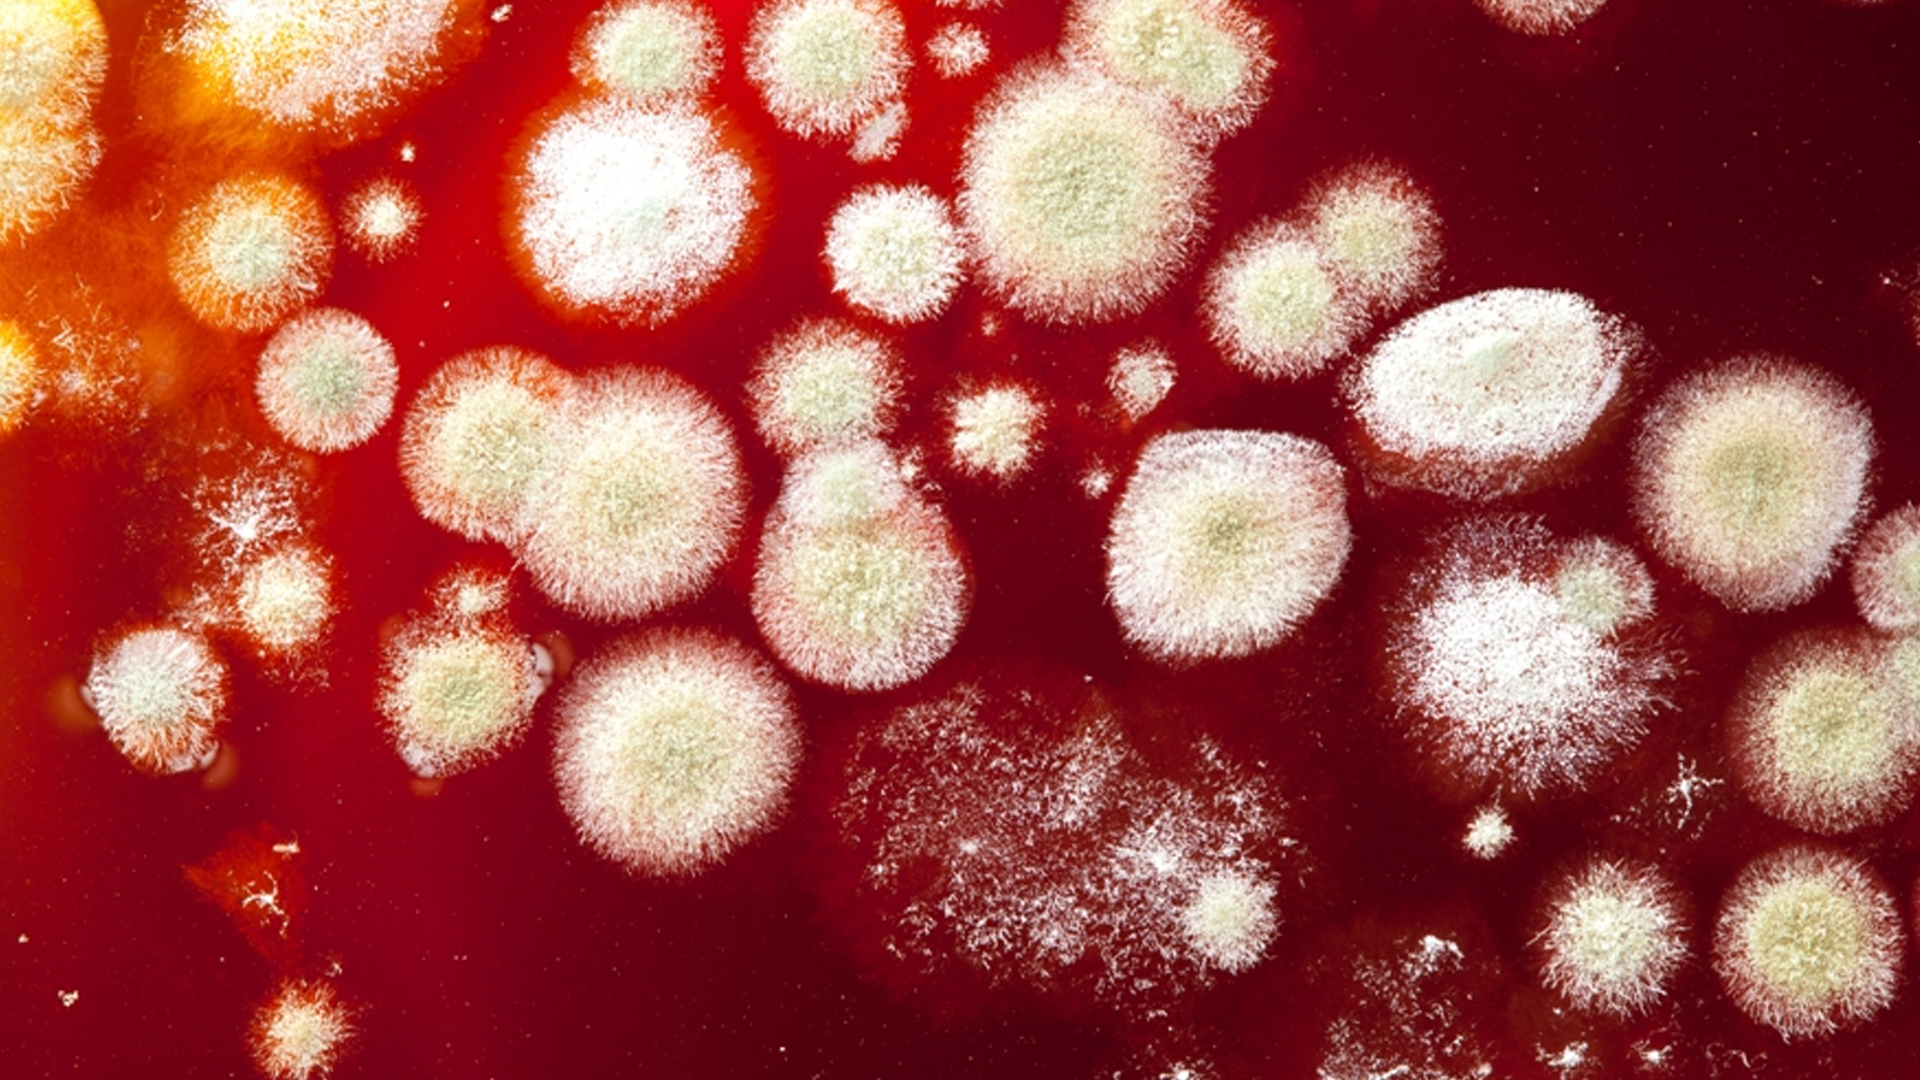
મ્યુકોર્માયકોસિસ (Deadly Fungal infection in COVID-19 patients)

Shree Multi Speciality Hospital
Address: A-1, 1st floor Shree Rang Society, palanpur patia, rander road,surat- 395009
Time: 11:00 AM to 01:30PM | 06:00 PM to 08:30PM

Dr. Sandeep Patel has stated his initial career Class I E.N.T surgeon at M.G general Hospital, Navsari. He Has Completed M.B.B.S and M.S (E.N.T) from Baroda Medical College, Baroda. He has total experience of 12 years. He has Expertise in FESS and skull base surgeries with training in Mumbai, Pune and Singapore and Expertise in OBSTRUCTIVE SLEEP APNAE SYNDROME with training in Hyderabad, Chennai and Singapore.

A purist's definition of mastoiditis includes all inflammatory processes of the mastoid air cells of the temporal bone. As the mastoid is contiguous to and an extension..

A nosebleed simply means that blood is coming out of the inside of the nose. Nosebleeds are one of the most common problems treated in an Emergency

Laryngeal cancers that form on the vocal cords (glottis) often cause hoarseness or a change in the voice. This can lead to them being found at a very early stage.


ઉત્સાહથી થનગનતા અને સારવારની નવી ટેકનોલોજીમાં રસરૂચિ ધરાવતા ડૉ. સાહેબ કહે છે, 'સાહેબના તબીબી અનુભવ અને પોતે કરેલા સંશોધન..
Read More
કોરોના મહામારીને એક વર્ષ વીતી ગયા બાદ પણ હજી લોકોમાં કોવિડ-19 અંગે માત્ર બિમારી પુરતી જ નહીં પરંતુ તેની ગંભીરતા, ચેપ, ખર્ચ, આડઅસરો પ્રત્યેની ચિંતા જોવા
Read MoreAddress: A-1, 1st floor Shree Rang Society, palanpur patia, rander road,surat- 395009
Time: 11:00 AM to 01:30PM | 06:00 PM to 08:30PM
Address: 3rd & 4th Floor, Shanti Point, Near Parag House, Above Kotak Bank, Udhna darwaja, Ring Road, surat
Time: 03:00 PM to 05:00PM
Copyright ©2021 Dr. Sanddep Patel. All Rights Reserved